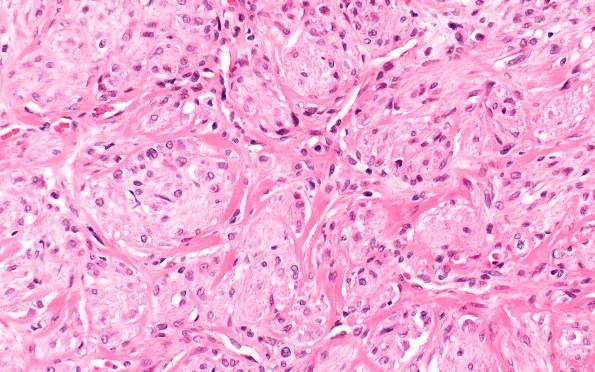
8A3 Neuroma, traumatic (Case 8) H&E 40X

Table of Contents
Washington University Experience | PERIPHERAL NEUROPATHY | 19 TRAUMATIC INJURIES | 8A3 Neuroma, traumatic (Case 8) H&E 40X
This is a classic neuroma shown with adjacent cross sections of the parent nerve. The neuroma varies in composition from haphazard elements (8A2) to mini-fascicles (8A3). (H&E)